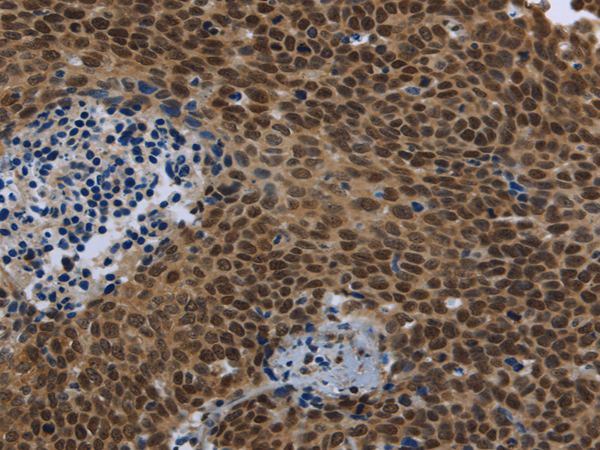
Anti-SMAD4

Cookie preferences
This website uses cookies, which are necessary for the technical operation of the website and are always set. Other cookies, which increase the comfort when using this website, are used for direct advertising or to facilitate interaction with other websites and social networks, are only set with your consent.
Configuration
Technically required
These cookies are necessary for the basic functions of the shop.
"Allow all cookies" cookie
"Decline all cookies" cookie
CSRF token
Cookie preferences
Currency change
Customer-specific caching
FACT-Finder tracking
Individual prices
Selected shop
Session
Comfort functions
These cookies are used to make the shopping experience even more appealing, for example for the recognition of the visitor.
Note
Show the facebook fanpage in the right blod sidebar
Statistics & Tracking
Affiliate program
Conversion and usertracking via Google Tag Manager
Track device being used
If you have any questions, please use our Contact Form.
You can also order by e-mail: info@biomol.com
Larger quantity required? Request bulk
You can also order by e-mail: info@biomol.com
Larger quantity required? Request bulk
This gene encodes a member of the Smad family of signal transduction proteins. Smad proteins are... more
Product information "Anti-SMAD4"
This gene encodes a member of the Smad family of signal transduction proteins. Smad proteins are phosphorylated and activated by transmembrane serine-threonine receptor kinases in response to TGF-beta signaling. The product of this gene forms homomeric complexes and heteromeric complexes with other activated Smad proteins, which then accumulate in the nucleus and regulate the transcription of target genes. This protein binds to DNA and recognizes an 8-bp palindromic sequence (GTCTAGAC) called the Smad-binding element (SBE). The Smad proteins are subject to complex regulation by post-translational modifications. Mutations or deletions in this gene have been shown to result in pancreatic cancer, juvenile polyposis syndrome, and hereditary hemorrhagic telangiectasia syndrome. Protein function: In muscle physiology, plays a central role in the balance between atrophy and hypertrophy. When recruited by MSTN, promotes atrophy response via phosphorylated SMAD2/4. MSTN decrease causes SMAD4 release and subsequent recruitment by the BMP pathway to promote hypertrophy via phosphorylated SMAD1/5/8. Acts synergistically with SMAD1 and YY1 in bone morphogenetic protein (BMP)-mediated cardiac-specific gene expression. Binds to SMAD binding elements (SBEs) (5'-GTCT/AGAC-3') within BMP response element (BMPRE) of cardiac activating regions. Common SMAD (co-SMAD) is the coactivator and mediator of signal transduction by TGF-beta (transforming growth factor). Component of the heterotrimeric SMAD2/SMAD3-SMAD4 complex that forms in the nucleus and is required for the TGF-mediated signaling. Promotes binding of the SMAD2/SMAD4/FAST-1 complex to DNA and provides an activation function required for SMAD1 or SMAD2 to stimulate transcription. Component of the multimeric SMAD3/SMAD4/JUN/FOS complex which forms at the AP1 promoter site, required for synergistic transcriptional activity in response to TGF-beta. May act as a tumor suppressor. Positively regulates PDPK1 kinase activity by stimulating its dissociation from the 14-3-3 protein YWHAQ which acts as a negative regulator. [The UniProt Consortium]
| Keywords: | Anti-DPC4, Anti-Smad4, Anti-SMAD4, Anti-SMAD 4, Anti-hSMAD4, Anti-MAD homolog 4, Anti-SMAD family member 4, Anti-Mothers against DPP homolog 4, Anti-Deletion target in pancreatic carcinoma 4, Anti-Mothers against decapentaplegic homolog 4, SMAD4 Polyclona |
| Supplier: | Elabscience |
| Supplier-Nr: | E-AB-16957 |
Properties
| Application: | WB, IHC, ELISA |
| Antibody Type: | Polyclonal |
| Conjugate: | No |
| Host: | Rabbit |
| Species reactivity: | human, mouse, rat |
| Immunogen: | Fusion protein of human SMAD4 |
| Format: | Purified |
Database Information
| KEGG ID : | K04501 | Matching products |
| UniProt ID : | Q13485 | Matching products |
| Gene ID : | GeneID 4089 | Matching products |
Handling & Safety
| Storage: | -20°C |
| Shipping: | 4°C (International: -20°C) |
Caution
Our products are for laboratory research use only: Not for administration to humans!
Our products are for laboratory research use only: Not for administration to humans!
Information about the product reference will follow.
more
You will get a certificate here
Viewed